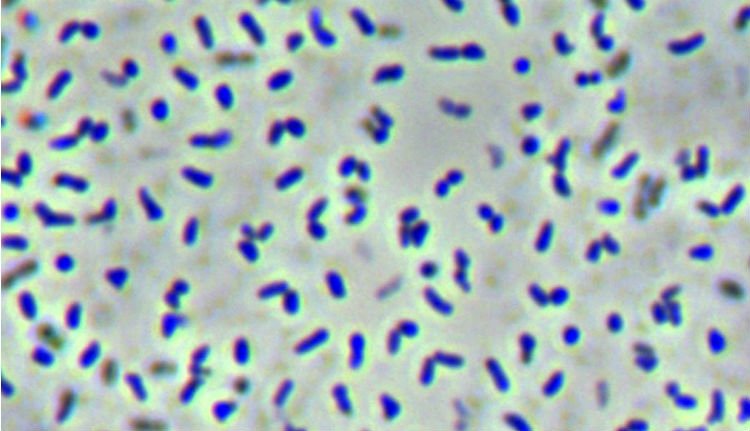

A Hargitának immár saját baktériuma is van
Az új bacit a cekendi hulladéktároló csurgalékvizéből tenyésztették ki a Sapientia mikrobiológusai.
A tudomány számára eddig ismeretlen új baktériumnemzetséget tenyésztettek ki és azonosítottak DNS-vizsgálatok alapján a Sapientia EMTE csíkszeredai Biomérnöki Tanszékén zajló mikrobiológiai kutatások során környezetmérnök szakos hallgatók, dr. Máthé István oktató vezetésével, a budapesti Eötvös Loránd Tudományegyetem (ELTE) oktatóival együttműködve – tudósít az egyetem közleménye.
A cekendi hulledéklerakó csurgalékvizéből származó új baktérium a Caenimicrobium hargitense nevet kapta. A nemzetségre vonatkozó első névben a latin „caeni” szó a csurgalékvizes reaktor eleveniszapjára utal, ahonnan a baktériumot kitenyésztették, a görög „microbium” szó pedig a magyar mikroorganizmus szó megfelelője. A „hargitense” fajnév a baktérium tágabb származási helyére, a Hargita-hegységre utal. Az izolált baktériumtörzs jó szénhidrát-, fehérje- és zsírbontó képességgel rendelkezik, így szerepet játszik a csurgalékvíz tisztításában.
A Caenimicrobium baktériumnemzetség közeli rokona az Eoetvoesia nemzetség, amely a nevét báró Eötvös Loránd magyar fizikus tiszteletére kapta.
Jelenleg világszerte mintegy 14000 baktériumfajt tartanak számon, azonban a szakemberek úgy vélik, hogy a Földünkön élő baktériumok döntő többsége (99%-a) jelenleg ismeretlen (azaz több mint egymillió faj), és csupán „genetikai ujjlenyomataik” alapján sejtjük ezeknek a mikrobáknak a létezését – fogalmaz a közlemény.
Generációk ellopott ifjúsága, avagy egy John Lydon nevű öreg punk a színpadon
Szántai János
Az öreg punk elővarázsolt egy fiatalembert, aki dühösen kérdőre vonta a közönséget. És nem tudtuk elmondani, hova lett a repülőgép, az Északi-sark, a büszke és szabad Magyarország és a többi…
Demeter András kicsinálása – szempontok egy igen gyorsan levezényelt, virtuóz akcióhoz
Fall Sándor
Azt nem tudni, hogy a lemondott miniszter ellen kik tervelték ki és hajtották végre az akciót, elképzelhető, hogy ez soha nem is fog kiderülni.
Az egyesült Nagy-Románia máig nem jelent egységesítést
Sólyom István
A mítosztalanított román–magyar közös történelem nem széles körű fogyasztásra alkalmas termék, de az MCC-történészkerekasztal előadói egyelőre optimisták.
„De hát én erdélyi vagyok, na” – a 90 éves Bodor Ádámot köszöntötték Kolozsváron
Varga László Edgár
Az író többek között arról beszélt, hogy ő „csak betévedt” az irodalomba, és arról is, milyen ambivalens érzésekkel tölti el a szülővárosába való visszatérés.

Száz nyestbőrrel a batyujában akart beutazni Romániába egy ukrán állampolgár – hírmix
Több mint félmilliárd lej eltitkolt vagyonra derített fényt az ANAF legújabb ellenőrzése. Népszavazással váltottak le egy Maros megyei polgármestert.

Németh Zsolt: elütött bennünket a varsói gyors, de a Fidesznek ismét szerethető alternatívává kell válnia (INTERJÚ)
Szerteágazó tünetegyüttes vezetett a Fidesz vereségéhez Németh Zsolt országgyűlési képviselő szerint, aki úgy véli, a választási eredmény nem tekinthető katasztrofálisnak, alapot jelent ahhoz, hogy a párt újjáépítse magát.

Nicușor Dan, a projektország hasznos idiótája
Többször leírtam: Románia egy projektország. Na és ebben a projektországban akkor van demokrácia, amikor a projekt megkívánja. Amikor nem, akkor nincs.

Elpusztított egy lovat és jött a tehénért is a behemót medve, amikor kilőtték
Kilőttek azt a medvét Gyergyószárhegy községben péntek hajnalban, amelyik az elmúlt napokban több alkalommal visszatért egy esztenához és haszonállatokat pusztított el.
„A magyarok is beszéljenek és írjanak románul”. Az anyanyelvhasználat ellen hergel egy AUR-os politikus
A magyar nyelv használata és a kétnyelvű feliratok ellen ágált egy videóban Lucian Mușat, a szélsőjobboldali Románok Egyesüléséért Szövetség (AUR) Szilágy megyei parlamenti képviselője, a megyei pártszervezet elnöke.

Megsebesítették, majd elmenekült a medve, és amikor újra felbukkant, akkor támadt
Kilőtték szerdán este azt a medvét Kászonban, amely hétfőn két embert sebesített meg egy esztenán. A nagyvad a hajtás során a vadőrre és a vadászra is rátámadt, ezért döntöttek a kilövése mellett.

Mégsem indul a PNL elnöki tisztségéért vasárnap Adrian Veștea – hírek szombaton
További híreink: hatvannyolcszoros, jobban mondva százharminchatszoros kutyafülcsonkításért állhat bíróság elé egy férfi, keddig pedig csak a záporok, szélviharok szakítják meg a kánikulát.

Mégsem indul a PNL elnöki tisztségéért vasárnap Adrian Veștea – hírek szombaton
További híreink: hatvannyolcszoros, jobban mondva százharminchatszoros kutyafülcsonkításért állhat bíróság elé egy férfi, keddig pedig csak a záporok, szélviharok szakítják meg a kánikulát.

Nicușor Dant Brüsszelből nem érdekli, hogy az AUR szavazataival állhat fel az új kormány…
… egy PNL-s főembert elvitt a DNA, az USR elnökére lesújtott Justitia kardja, az RMDSZ-re a botránytévék hányják a gyűlöletet… és tíz román állampolgár egymillió eurónyi drótot lopott Németországban.

Nicușor Dant Brüsszelből nem érdekli, hogy az AUR szavazataival állhat fel az új kormány…
… egy PNL-s főembert elvitt a DNA, az USR elnökére lesújtott Justitia kardja, az RMDSZ-re a botránytévék hányják a gyűlöletet… és tíz román állampolgár egymillió eurónyi drótot lopott Németországban.

Akkora a kupi kormányalakítás körül, hogy ember legyen a talpán, aki átlátja – hírek csütörtökön
Közben Románia Szlovákiával közösen kéri, hogy az Európai Bizottság lazítson a medvéket védő szabályozásokon. Nyárádszeredában pedig tranzitdíjat vezettek be a kamionokra, a lépés az ott épülő autópályát is érinti.

Akkora a kupi kormányalakítás körül, hogy ember legyen a talpán, aki átlátja – hírek csütörtökön
Közben Románia Szlovákiával közösen kéri, hogy az Európai Bizottság lazítson a medvéket védő szabályozásokon. Nyárádszeredában pedig tranzitdíjat vezettek be a kamionokra, a lépés az ott épülő autópályát is érinti.

Kiengedték a börtönből Horațiu Potrát, Călin Georgescu zsoldosvezérét – hírmix
További híreink: a jelek szerint Adrian Veștea kormányalakítási kísérlete is halva született, de legalább egyre nagyobb a káosz, ha pedig súlyos inflációról van szó, Románia mindenkit toronymagasan megelőz.

Kiengedték a börtönből Horațiu Potrát, Călin Georgescu zsoldosvezérét – hírmix
További híreink: a jelek szerint Adrian Veștea kormányalakítási kísérlete is halva született, de legalább egyre nagyobb a káosz, ha pedig súlyos inflációról van szó, Románia mindenkit toronymagasan megelőz.

Nem támogatja az RMDSZ Veșteát, két új forgatókönyv is körvonalazódik kormányalakításra – hírmix
Szennyezett kavicsot használtak fel útjavításra egy Bihar megyei faluban, feljelentették a polgármestert. A romániai textilipar súlyos megrendelési visszaesésekkel küzd egy EU-s szabályozást követően.

Nem támogatja az RMDSZ Veșteát, két új forgatókönyv is körvonalazódik kormányalakításra – hírmix
Szennyezett kavicsot használtak fel útjavításra egy Bihar megyei faluban, feljelentették a polgármestert. A romániai textilipar súlyos megrendelési visszaesésekkel küzd egy EU-s szabályozást követően.

Száz nyestbőrrel a batyujában akart beutazni Romániába egy ukrán állampolgár – hírmix
Több mint félmilliárd lej eltitkolt vagyonra derített fényt az ANAF legújabb ellenőrzése. Népszavazással váltottak le egy Maros megyei polgármestert.

Száz nyestbőrrel a batyujában akart beutazni Romániába egy ukrán állampolgár – hírmix
Több mint félmilliárd lej eltitkolt vagyonra derített fényt az ANAF legújabb ellenőrzése. Népszavazással váltottak le egy Maros megyei polgármestert.

Adrian Veștea PNL-s politikust kérte fel az államfő kormányalakításra, a párt megkérdezése nélkül – hírek
Előbb esőzések és szélviharok, aztán kánikula jön országszerte. Továbbá sikerült kompromisszumot kötni a lengyel gyártóval: a pályaudvaron rekedt új vonatokat napokon belül üzembe helyezik.

Adrian Veștea PNL-s politikust kérte fel az államfő kormányalakításra, a párt megkérdezése nélkül – hírek
Előbb esőzések és szélviharok, aztán kánikula jön országszerte. Továbbá sikerült kompromisszumot kötni a lengyel gyártóval: a pályaudvaron rekedt új vonatokat napokon belül üzembe helyezik.

Rossz napjai vannak Eugen Tomacnak: az USR és úgy hírlik, az RMDSZ is hátat fordított neki…
… leomlott a szászmuzsnai evangélikus erődtemplom falának egy része… és nyolc év után hamarosan új autópálya-szakaszt avatnak Erdélyben, ha minden jól megy.

Rossz napjai vannak Eugen Tomacnak: az USR és úgy hírlik, az RMDSZ is hátat fordított neki…
… leomlott a szászmuzsnai evangélikus erődtemplom falának egy része… és nyolc év után hamarosan új autópálya-szakaszt avatnak Erdélyben, ha minden jól megy.

A hűtőbe is benézett a nyolc házat feldúló medve – hírmix
A kőolaj- és földgázkitermelésben dolgozók keresnek a legjobban Romániában. Ezentúl akár 12 000 lejre is megbírságolhatják a csendháborítókat.

A hűtőbe is benézett a nyolc házat feldúló medve – hírmix
A kőolaj- és földgázkitermelésben dolgozók keresnek a legjobban Romániában. Ezentúl akár 12 000 lejre is megbírságolhatják a csendháborítókat.

A PNL vezérkara egy emberként mutatott fityiszt a leendő Tomac-kormánynak…
… Románia kérni fogja Brüsszelben, vegyék már le a medvét a szigorúan védett fajok listájáról… és befutott a gigaszámla a Pfizertől a megrendelt, majd visszautasított Covid-ellenes vakcinákkal kapcsolatban.

A PNL vezérkara egy emberként mutatott fityiszt a leendő Tomac-kormánynak…
… Románia kérni fogja Brüsszelben, vegyék már le a medvét a szigorúan védett fajok listájáról… és befutott a gigaszámla a Pfizertől a megrendelt, majd visszautasított Covid-ellenes vakcinákkal kapcsolatban.
Generációk ellopott ifjúsága, avagy egy John Lydon nevű öreg punk a színpadon
Szántai János
Az öreg punk elővarázsolt egy fiatalembert, aki dühösen kérdőre vonta a közönséget. És nem tudtuk elmondani, hova lett a repülőgép, az Északi-sark, a büszke és szabad Magyarország és a többi…
Demeter András kicsinálása – szempontok egy igen gyorsan levezényelt, virtuóz akcióhoz
Fall Sándor
Azt nem tudni, hogy a lemondott miniszter ellen kik tervelték ki és hajtották végre az akciót, elképzelhető, hogy ez soha nem is fog kiderülni.
Az egyesült Nagy-Románia máig nem jelent egységesítést
Sólyom István
A mítosztalanított román–magyar közös történelem nem széles körű fogyasztásra alkalmas termék, de az MCC-történészkerekasztal előadói egyelőre optimisták.
„De hát én erdélyi vagyok, na” – a 90 éves Bodor Ádámot köszöntötték Kolozsváron
Varga László Edgár
Az író többek között arról beszélt, hogy ő „csak betévedt” az irodalomba, és arról is, milyen ambivalens érzésekkel tölti el a szülővárosába való visszatérés.







